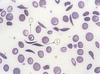
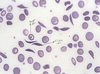
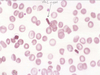
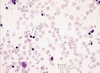
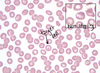

15 - Hemoglobin Disorders Flashcards
(42 cards)
What are the 2 classes of hemoglobin disorders?
- structural variants
(abnormal globin chain structure due to globin gene mutation; varied clinical effect depending on location and nature of mutation) - thalassemias
(under-production of structurally normal globin chains; generally microcytic/hypochromic anemais of varying severity)
What are the two main globin gene clusters?
- alpha cluster on chromosome 11
(2 alpha, 1 theta, 2 psi, and 2 zeta genes) - beta cluster on chromosome 16
(1 beta, 1 delta, 2 gamma, 1 epsilon gene)

What are the 3 normal hemoglobin species? What are the percentages in a normal adult?
- Hb A (2alpha2beta)
*96% in adults - Hb A2 (2alpha2delta)
*3% in adults - Hb F (2alpha2gamma)
*dominates during fetal life, 1% in adults

What is the incidence of abnormal hemoglobin? What are the usual clinical symptoms?
- 500+ structural hemoglobin variants (mostly single amino acid replacements, occasionally deletions/insertions)
- mostly clinically silent with no functional consequences
What are some examples of clinical consequences caused by abnormal hemoglobin?
- sickling
- Hb instability
- altered oxygen affinity (increased or decreased)
- increased susceptibility to oxidation (to methemoglobin)
- under-production of globin chains
- combinations of the above
What are the 2 main laboratory techniques for diagnosing abnormal hemoglobin?
- electrophoresis (gel or capillary)
- HPLC (high performance liquid chromatography)
Describe hemoglobin electrophoresis
- typically performed in parallel with alkaline and acid buffers
- HbA has isoelectric point of 6.8
- neg charge in alkaline buffers, migrates towards anode (+)
- pos charge in acid buffers, migrates towards cathode (-)

Describe HPLC
- fully automated cation exchange chromatography method
- whole blood method:
- Hb adsorbed onto resin particles
- different species differentially eluted based on affinity for resin by gradually changing ionic strength of elution buffer
- some correlation with migration on alkaline electrophoresis

Describe sickle cell disease
- homozygous abnormality of the beta globin chain
- more common in african americans (1 in 600 homozygous)
- Glu -> Val substitution at AA 6 of the beta chain (beta6val)
- heterozygous HbS “S trait” confers protection against malaria
Describe the pathophysiology of sickle cell disease
- deoxygenated HbS forms long polymers that distort the shape of the cell into an elongated, sickled form
- extend of polymerization is time and concentration dependent
- initially reversible but after multiple sickling/unsickling cycles, membrane damage produces irreversibly rigid sickled cell
- RBC lifespan decreased to 20 days
What affects the concentration of HbS?
- percentage of HbS of total Hb:
- homozygous or heterozygous
- presence of other Hb species (e.g. Hb F)
- total Hb concentration in the red cells (MCHC; Mean corpuscular hemoglobin concentration)
- concentration increased in cellular dehydration
- concentration decreased when co-existent thalassemia
What factors influence the time dependence of sickling?
- transit time of red cells through low oxygen tension microvasculature
- sickling enhanced in anatomic sites with sluggish flow (e.g. spleen and bone marrow)
- blood flow thorugh microvasculature retarded in certain pathologic states (e.g. inflammation)
What clinical settings predispose a patient to sickling?
- hypoxia
- acidosis (shift dissociation curve to the right causing increased deoxygenation of HbS)
- dehydration (hypertonicity causing RBC dehydration)
- cold temperatures (sluggish blood flow)
- infections
What are 2 major effects of RBC sickling?
- chronic hemolysis (correlates with the number of irreversibly sickled cells)
- microvascular occlusion with resultant tissue hypoxia and infarction (related to increased “stickiness” of SS red cells because of membrane damage)
When do symptoms usually begin for a patient with sickle cell?
- newborns clinically fine because of high HbF
- hematologic manifestations begin by 10-12 weeks of age
- clinical severity variable from patient to patient
What are 6 common clinical manifestations of sickle cell disease?
- severe anemia
- acute pain crises (from vaso-occlusion)
- auto-splenectomy (from repeat splenic infarction)
*increases infection risk - acute chest syndrome (major cause of death from pulmonary infections or fat emboli)
- strokes (first usually when 2-8 years old)
- aplastic crisis (acute decrease in RBC production usually from parvovirus B19 infection “fifths disease”)
What are the laboratory findings in sickle cell disease?
- chronic anemia (Hb 5-11 g/dl)
- increased bilirubin
- sickled cells, target cells, polychromasia
- increased reticulocytes
- normal MCV
What does this blood smear show?
**sickle cell disease
- target cell
- sickled cell
What would the gel electrophoresis results look like for sickle cell disease?
In class she stressed to KNOW THIS!
**bands for S and F hemoglobin (along with the normal A and A2 bands)

What would the HPLC results look like for sickle cell disease?
Large spikes for Hb S and F (note lack of A spike)

What are the other 2 main sickling disorders?
- Hb SC disease
- compound heterozygous state
- Hb C from glu6lys substitution of the beta globin
- generally milder than SS but highly variable
- Hb S/beta thalassemia
- heterozygous Hb S with trans beta thalassemia allele, resulting in decreased or absent production of normal beta chains
- asymptomatic to nearly identical to SS
- lab findings= Hb S > Hb A
How do you manage a patient with sickle cell disease?
- newborn screening
- infection prophylaxis
- supportive care for acute manifestations
- hydroxyurea (chemo to reduce RBC counts and increase HbF levels)
- regular red cell transfusions
- allogeneic stem cell transplant (the only curative therapy but it’s only used in very sick patients)
What is the outcome for a patient with sickle cell disease?
- median age of death= 45 for males, 48 for females
- although much better than <20 year expectancy in the 1970’s
- gains due to decreased child mortality (infection prophylaxis and comprehensive care)
- major causes of death:
- liver dysfunction
- pulmonary HTN
- stroke/vaso-occlusive crisis
- acute chest syndrome
What is S-trait?
- clinically benign carrying of sickle cell gene (in 8% of african americans)
- no anemia/normal RBC survival
- NO sickling
- may be mild, sub-clinical kidney damage
- lab values= 60% Hb A, 40% HbS